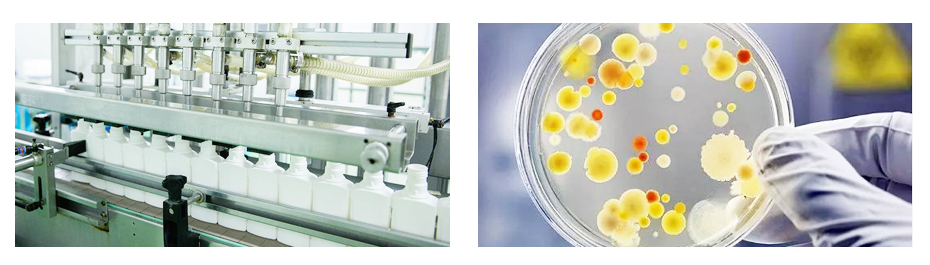

日用化學品行業生產用純水設備解決方案
- 來源:
- 君浩環保集團
- 瀏覽:
- 2929
- 發布日期:
- 2023-06-19
使用純水設備的好處

日用化學品行業純水設備工藝說明

日用化學品行業純水設備詳細介紹

日用化學品行業純水設備解讀
日化行業常用的化妝品、洗護用品等產品需要使用高純度的水作為原材料或生產過程中的輔助用水。因為含有雜質、微生物、有機物質等的水會對產品質量帶來不良影響,甚至可能導致過敏、感染等健康問題。同時,使用高純度水可以減少設備損壞、降低生產成本、提高產品品質和工藝效率等綜合效益。因此,日化行業使用純水設備可以有效的保證產品的質量和安全,并提高生產效率和節約成本。
日用化學品行業純水設備達標要求
 生產用水標準
生產用水標準
GB/T 17219-1998《工業用水純化技術》:這是中國國家標準,規定了各種類型的工業用水的純化方法和指標,包括日化行業用純水設備。
可根據客戶需求定制,出水達行業用水標準
君浩環保六大優勢

水處理系統一站式解決方案










 陜公網安備 61040202000640號
陜公網安備 61040202000640號